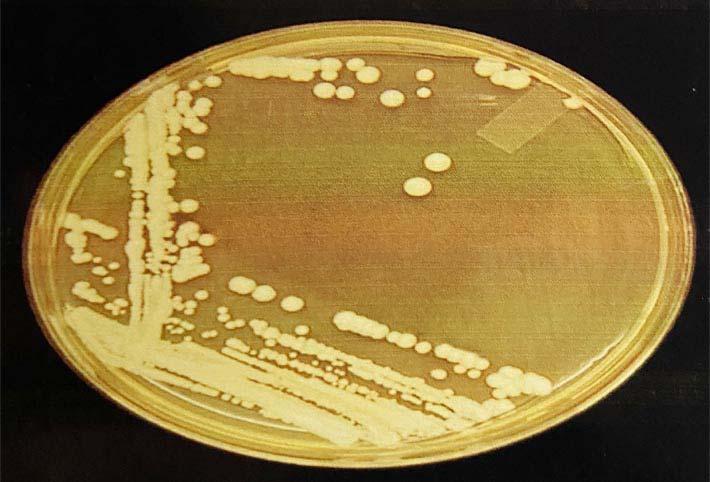

15 minute read
Nawal Kishore Jha
from August 2020
by Ejima
JOURNAL OF THE INDIAN MEDICAL ASSOCIATION, VOL 118, NO 08, AUGUST 2020
Advertisement
Amrisha Sharan 1 , Dipendra Kumar Sinha 2 , Nawal Kishore Jha 3
Introduction : Candida isolation from intra operative peritoneal fluid in cases of hollow organ perforation is a significant risk factor for post-operative morbidity and mortality. The present study analyses the frequency of fungal isolation and its implications on post-operative course in patients with hollow viscus perforation.
Material and Methods : This prospective observational clinical study was conducted from April 2014 to November 2015 at our institute after approval from the institute’s ethics committee. The study population was selected from the patients presenting to the surgical emergency department with nontraumatic perforation peritonitis.The peritoneal fluid was collected during exploratory laprotomy and sent for microbiological analysis.
Results : The total number of cases included in the study was 127. A total of 44 samples positive for fungus. All of the fungi isolated belonged to Candida species. 77.3% (n=34) of the Candida isolated were Albicans and 22.7% (n=10) were Non-Albicans.
Conclusion : Prompt identification and empirical use of antifungal along with wide spectrum antibiotics may help the patients with non traumatic hollow viscus perforation to recover early.
[J Indian Med Assoc 2020; 118(8): 38-41]
Key words : Peritonitis, Fungus, Candida.
Peritonitis is a spectrum with varied aetiology and clinical course. Primary peritonitis occurs in young females and cirrhotic and is typically mono-microbial in nature. It consists of bacteria from genital tract in former cases and translocated gut bacteria in latter. Secondary peritonitis is more common and a result of anatomic breach of the gastrointestinal tract. The microbial flora is from the adjacent gut and is polymicrobial in nature. It also results from infection due to indwelling catheters, ventriculo-peritoneal shunt and direct extension from retroperitoneal infection. A clinical syndrome evolves with recurrent peritonitis after apparent control of primary or secondary peritonitis due to organisms of low intrinsic pathology. This has been termed tertiary peritonitis.
The gastrointestinal tract is a major reservoir of Candida species and an important portal for intraabdominal and disseminated candidiasis. As a commensal of the digestive tract, Candida may leak into the peritoneal cavity after perforation of a hollow viscus or surgical section of the intestinal wall. However, under most circumstances, Candida is cleared quickly from the peritoneum. Nevertheless, in some patients,
Department of General Surgery, Rajendra Institute of Medical
Sciences, Ranchi, Jharkhand 834009 1 MS (Gen Surg), Senior Resident and Corresponding Author 2 MS, Professor 3 MS, Professor & Head
Received on : 27/02/2020 Accepted on : 11/07/2020 Editor's Comment :
Fungal cultures of peritoneal fluid samples obtained
intra operatively should be routinely done in the treatment of patients of perforation peritonitis along with bacterial culture.
Positive peritoneal fluid fungal cultures is a significant
risk factor for poor outcome.
Antifungal should be used along with wide spectrum
antibiotics in patients with non-traumatic hollow viscus perforation to ensure early recovery.
peritoneal seeding results in the development of an intra-abdominal Candida infection, with a risk of dissemination to the bloodstream and to extraabdominal tissues and organs.
The most frequently implicated risk factors include the use of broad-spectrum antibacterial agents, use of central venous catheters, receipt of parenteral nutrition, receipt of renal replacement therapy by patients in ICUs, neutropenia, and receipt of immunosuppressive agents (including glucocorticosteroids, chemotherapeutic agents, and immune-modulators) 1 . Patients with health care-associated intra-abdominal infection are at higher risk of Candida peritonitis, particularly patients with recurrent gastrointestinal perforations and surgically treated pancreatic infection.
Candida isolation from intra operative peritoneal fluid in cases of hollow organ perforation is a significant risk factor for post-operative morbidity and mortality 2 .
38
JOURNAL OF THE INDIAN MEDICAL ASSOCIATION, VOL 118, NO 08, AUGUST 2020
The present study analyses the frequency of fungal isolation and its implications on post-operative course in patients with hollow viscus perforation.
M ATERIAL AND METHODS
This prospective observational clinical study was conducted from April 2014 to November 2015 at our institute after approval from the institute’s ethics committee. The study population was selected from the patients presenting to the surgical emergency department with non traumatic perforation peritonitis. Patients developing peritonitis due to anastomotic leak during hospital stay were also included. The patients who have received any form of antifungal treatment in past one month have been excluded.
The peritoneal fluid was collected during exploratory laprotomy and sent to the microbiology lab for examination. For bacterial culture the sample was inoculated in Blood Agar and MacConkey Agar at 37 degree Celsius for 48 hours. The colony characteristics and bacterial motility were examined. Gram staining was done. Bacterial identification was done by Indole, Methyl Red, Voges Proskaeur and Catalase (IMViC) tests. Antimicrobial susceptibility test (AMST) was done.For fungal culture, the sample was inoculated on Sabouraud’s Dextrose Agar at 37 degree Celsius for 7 days (Fig 1). A colony smear was done to identify fungi. Germ tube test was done by inoculating a yeast colony into 1 ml of human serum and incubating it at 37 degree Celsius for 2 hours. A KOH mount was prepared at the end of 2 hours and filamentous outgrowths could be seen extending from yeast cells if the fungus was of Candida species. As germ tube test is positive for Candida albicans, the candida with germ tube negative results were reported as Candida non albicans. Anti-fungal susceptibility could not be done due to non-availability.
R ESULTS
The total number of cases included in the study was 127. The age range was from 5 years to 73 years with mean age of 39.5 years. There were 26 patients who were more than 50 years age. The population under study included 23.6% (n=30) females and 76.4%(n= 97) males. The average age of females in the sample was 40.1, while the average age of males was 39.Of the 127 patients 76 (59.8%) patients came to the hospital after 24 hours of onset of symptoms.The remaining 51 (40.2%) patients presented to the hospital within 24 hours of onset of symptoms.29.9% (n=38) patients had received pre-operative antibiotic therapy for a duration of more than 48 hours.The rest 70.1% (n=89) had either received antibiotics for less than 48 hours before undergoing surgery for perforation peritonitis or one pre-operative dose of antibiotic. 39
The Duodenum was the commonest site of perforation (n=65) (Fig 2), followed by ileal (n=30) (Fig 3), gastric (n=12), appendicular (n=15) and colonic perforation (n=5). The total gastroduodenal perforations were 77.
Of the 127 peritoneal fluid samples cultured, 90 (70.9%) were culture positive and 37(29.1%) were sterile. The total samples positive for fungal culture were 44(34.6%). Only bacteria were present in 46 cases (36.2% of all samples). All 44 (34.6%) fungal culture positive samples were also positive for bacteria.Of the 90 culture positive samples, 34 (37.8%) were mono-microbial and 56 (62.2%) had more than one microbe isolated. Thus, 26.7% of the total sample (127) was mono-microbial and 44.1% was polymicrobial.
A total of 44 samples positive for fungus. All of the fungi isolated belonged to Candida species. 77.3% (n=34) of the Candida isolated were Albicans and 22.7% (n=10) were Non-Albicans.
Of the total samples, E coli was the most frequently isolated, being present in 61/127 (48.03%) of all samples. Gram positive cocci were present in 49/127 (38.58%) of all samples. Klebsiella was found in 7/ 127 (5.51%) of all samples. Pseudomonas was present in 6/127 (4.72 %) of the total sample.
D ISCUSSION
A total of 127 patients were included in this study after taking proper consent, out of which 24 % were females and 76% were males. Worldwide there is predominance of males presenting with this life threatening problem, our study also shows a similar trend. The mean age of the sample was 39.5 years. Of the total patients, 59.84% presented to the hospital 24 hours after onset of symptoms. Of the total patients 29.82% of the patients had been administered antibiotics for more than 48 hours before surgery.
In this study, the commonest site of gastrointestinal perforation was the duodenum (51.18%), followed by
Fig 1 — Candida Albicans colony on Sabourauds Agar
ileum (23.62%), appendix (11.81%),stomach (9.44%)
JOURNAL OF THE INDIAN MEDICAL ASSOCIATION, VOL 118, NO 08, AUGUST 2020
and colon (3.93%). In total, gastroduodenal perforations accounted for 65.09% of all cases. This is comparable to the sample in the study done by Prakash et al 1 in 2008 where gastroduodenal perforations accounted for 70% of all perforations and Jindal et al 2 in 2015 where gastroduodenal perforation was the commonest site(48.7%).
The results of the present study showed that 70.8% of the samples were culture positive and the rest (21.9 %) were sterile. This is comparable to Jindal et al where the culture positivity was 73.5% but lower than in the study by Prakash et al and Lee et al 3 in 2002 where around 50 % of the samples were culture positive. The study by Prakash et al had a smaller sample size and Lee et al 3 studied only peptic ulcer perforation. This could be the reason for the difference in frequency of culture positive samples.
In the present study, the prevalence of Aerobic gram negative bacteria was 56.69 %. de Ruiter et al 4 in 2009 found 52.9% Aerobic gram negative bacteria which is similar to our results. The commonest aerobic gram negative bacteria isolated in their study were E.coli (45%). Of the 221 samples they cultured, 42.5 % had gram positive cocci. In our study we found 48% E.coli and 38.5% gram positive cocci which is similar to their results.
In our study, 34.6% (44 of 127) of the samples had positive fungal culture. All of the fungi isolated were of Candida species. Various studies have reported the incidence of fungi from 1 to 49%.Prakash et al have reported prevalence of 30.9% and Jindal et al have reported a prevalence of 48.6% of fungal isolation in peritoneal fluid of patients with peritonitis due to hollow viscus perforation. De Ruiter et al reported a frequency of 19.9% for fungal isolation in hollow organ perforation.
In the present study, the frequency of fungal isolation was 44.6% in duodenal perforation, 50% in gastric perforation, 26% in ileal perforation and 20% in colonic perforation. Lee et al studied the incidence 40

of fungal peritonitis in peptic ulcer perforation. They found a fungal isolation with a frequency of 37.09 % in peptic ulcer perforation cases. Shan et al 5 in 2002 found 43.4% fungal isolation in cases of peptic ulcer perforation. De Ruiter et al found it to be 41% in perforated peptic ulcer. Jindal et al reported a prevalence of 70.5% candida isolation in gastroduodenal perforation whereas Prakash et al reported it to be 23%. The findings are variable in all studies.
In the present study, the rate of fungal isolation in ileal perforation was 26%. Jindal et al found it to be 32.8% and Prakash et al reported it to be 77%. There was no fungal positivity in appendicular perforation similar to the results found by de Ruiter et al and Jindal et al. In colonic perforation, fungal positivity was found to be 25% by Jindal et al and 11.8% by de Ruiter et al. Our study found the prevalence of positive fungal culture in colonic perforation to be 20%. The differences in results could be because of different geographical location and patient profile.
Shan et al reported age, preoperative organ failure, delay in operation, high Mannheim Peritonitis Index (MPI) and Acute Physiology and Chronic Health Evaluation (APACHE) II scores, and preoperative antibiotic therapy as risk factors for a positive fungal culture. Dupont et al 6 in 2003 found four independent risk factors of yeast isolation in peritoneal fluid (similar odds ratio) in a retrospective cohort: female gender, upper gastrointestinal tract origin of peritonitis, intraoperative cardiovascular failure, and previous antimicrobial therapy at least 48 hours before the onset of peritonitis.
In the present study, we found a significant difference between proportion of age more than or equal to 50 and less than 50 with fungal isolation. In our study, there was significant difference between proportions of males with fungal isolation to females. However in our study, the difference between patients who had a delayed presentation with fungal isolation
Fig 2 — Intra operative image of duodenal perforation
and those without a delay and fungal isolation was not

Fig 3 — Intra operative image of illeal perforation
JOURNAL OF THE INDIAN MEDICAL ASSOCIATION, VOL 118, NO 08, AUGUST 2020
significant. In our study we also found a significant difference between proportions of Pre-operative antibiotic use of more than 48 hours with fungal isolation to Pre-operative antibiotic use of less than 48 hours. There was a significant relationship between site of perforation and isolation of fungus, the commonest site of isolation being gastroduodenal. These results are comparable to the studies mentioned above. The relationship between delay and presentation more than 24 hours and fungal isolation was not significant which is different from the previous studies. As the usual standard of care all patients were given appropriate antibiotics based on culture sensitivity results and I.V. fluconazole if fungal isolates were present. In the post-operative period surgical site infection was present in 68.16% of fungal positive cases, 43.47% in only bacteria positive and 24.32% in patients with sterile cultures. These results are comparable to Jindal et al who found SSI in 76.5% of patients with fungal positive cultures.The proportion of patients with SSI was significantly larger for patients with positive fungal culture when compared to the patients with no fungus isolated in our study sample. In our study, hospital stay of more than 15 days was seen in 72.72% of fungal positive, 45.65% of bacterial positive and 10.8 % of sterile cultures.This result is comparable to Jindal et al who found 72% patients with fungal culture positive results having prolonged hospital stay.The proportion of patients with duration of hospital stay of more than 15 days was significantly larger for patients with positive fungal culture when compared to the patients with no fungus isolated in the sample in our study. We found an overall mortality of 10.23 %, with fungal positive cases having a mortality of 22.7% and only bacteria positive cases with 6.5% mortality. The fungal positive cases were responsible for 76.92% and bacterial only were responsible for 23.09% of overall mortality. Overall mortality found by Jindal et al was 8.5%, Prakash et al was 35.7% and Lee et al was 9.6%. In the fungal positive cases the mortality was 21.7% in the study by Lee et al, 76% by Prakash et al, 14.7 % by Jindal et al and 13% by Khan et al 7 . Our findings are comparable to these results. In our study, the proportion of patient mortality was significantly larger for patients with positive fungal culture when compared to the patients with no fungus isolated in the sample. Shan et al found a significant relationship between fungal isolation and incidence of surgical site infections, hospitalization and mortality. Lee et al concluded that fungal isolation was not a significant risk factor for mortality. Prakash et al found that Candida co infection was a bad prognostic factor.Jindal 41 et al found that patients with positive fungal culture had higher incidence of surgical site infection, residual abscess formation, longer intensive care unit stay, longer hospital stay and higher mortality rates in comparison to fungal culture negative patients and results were statistically significant. We found that there was a statistically significant relationship between fungal isolation and surgical site infection, prolonged hospital stay and mortality.
In a stepwise multivariate logistic regression,age of patients and pre-operative antibiotic use for more than 48 hours were the most significant independent variables associated with the isolation of fungus in the sample. The third important variable associated with fungal isolation was sex of the patients in our study sample.
CONCLUSION
The incidence of fungal infection in non-traumatic hollow viscus perforation is quite high. It can thus be concluded that bacterial as well as fungal cultures and antimicrobial sensitivities of peritoneal fluid samples obtained intraoperatively should be routinely done in the treatment of patients of perforation peritonitis. There is high prevalence of positive peritoneal fluid fungal cultures in Institutional set up and fungus is a significant risk factor for poor outcome in these patients. Hence, surgeons should be made aware of the usefulness of fungal culture along with bacterial culture of intra operative peritoneal fluid samples and utility of antifungal therapy in the treatment of gastrointestinal perforation.It may also be the leading cause for increased morbidity and mortality in patients in extreme of ages. Prompt identification and empirical use of antifungal along with wide spectrum antibiotics may help the patients with non-traumatic hollow viscus perforation to recover early.
Funding : None
REFERENCES
1 Prakash A,Sharma D, Saxena A, Somashekar U, et al — Effect of Candida infection on outcome in patients with perforation peritonitis. Indian J Gastroenterol 2008; 27: 107-9. 2 Jindal N, Arora S, Pathania S — Fungal Culture Positivity in
Patients with Perforation Peritonitis. J Clin Diagn Res 2015; 9(6) : DC01-3 3 Lee SC, Fung CP, Chen HY, et al — Candida peritonitis due to peptic ulcer perforation: incidence rate, risk factors, prognosis and susceptibility to fluconazole and amphotericin B. Diagn
Microbiol Infect Dis 2002; 44: 23-7. 4 de Ruiter J, Weel J, Manusama E, et al — The epidemiology of intra-abdominal flora in critically ill patients with secondary and tertiary abdominal sepsis. Infection 2009; 37: 522-7 5 Shan YS, Hsu HP, Hsieh YH, et al — Significance of intraoperative peritoneal culture of fungus in perforated peptic ulcer. Br J Surg 2002; 90: 1215-9. 6 Dupont H, Bourichon A, Paugam-Burtz C etal.Can yeast isolation in peritoneal fluid be predicted in intensive care unit patients with peritonitis? Critical Care Med 2003; 31: 752-7
Conflict of Interest : None







